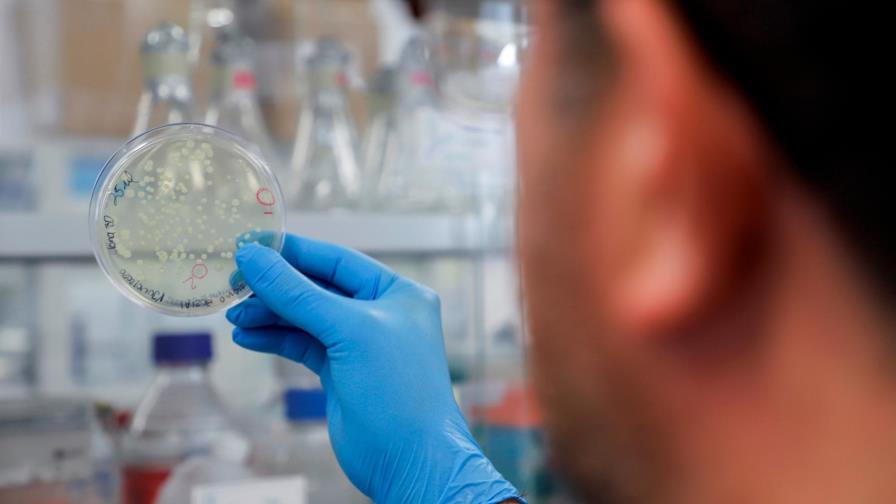
Investigadores descubren una posible nueva variante del COVID-19 en Bélgica

Investigadores descubren una posible nueva variante del COVID-19 en Bélgica
Subrayan que esta nueva variante “aún no suscita ninguna preocupación especial sobre su peligrosidad”
Investigadores de la Universidad de Lieja descubrieron el pasado enero una nueva mutación del virus Sars-Cov-2, responsable del COVID-19, cuyos efectos aún se desconocen, según informó este lunes el diario belga Le Soir.
La nueva mutación, conocida como Spike Insertion (SI) y cuyo nombre científico es B.1.214, no está clasificada aún como “variante preocupante” (VOC), como sí lo están la llamada variante británica (B.1.117), la variante sudafricana (B.1.351) y la variante brasileña (P.1).
Al contrario que dichas variantes, la mutación descubierta en Bélgica se ha producido a través de la inserción de nueve nucléotidos a la secuencia de la proteína del virus, mientras que las anteriores se crearon por supresiones en el genoma, según explicó a Le Soir Vicent Bours, responsable del laboratorio de análisis y secuenciación del virus Sars-Cov-2 en la Universidad de Lieja.
Sin embargo, los investigadores subrayaron que esta nueva variante “aún no suscita ninguna preocupación especial sobre su peligrosidad” y que no se sabe si ofrece alguna ventaja al virus original en términos de transmisibilidad.
Esta posible variante representa ya el 4 % de los contagios de las muestras observadas, más o menos lo mismo que las variantes sudafricana y brasileña, mientras que la británica constituye en este momento entre el 70 y el 75 % de los contagios en Bélgica, según los investigadores.
No obstante, “podemos ver que está aumentando progresivamente en Bélgica, sobre todo en Bruselas, el Brabante Flamenco y Henao, pero estamos casi seguros de que no es una cepa belga”, explicó Bours, que comentó que esta variación “podría proceder del África subsahariana y se habría implantado en nosotros a través de los viajes”.



 EFE
EFE